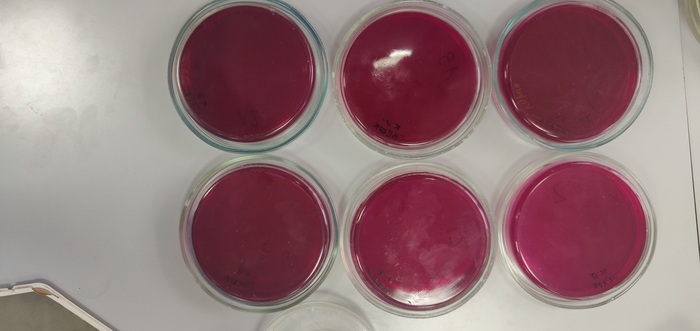

Ответ на пост «Ачивки учителя биологии»
Ачивки инженера-проектировщика.
Не так смешно, как у специальностей, завязанных на общении, но так же жизненно.
1. Speak faster!
Закончить перевод альбома проектной документации меньше, чем за день. (Не очень относится к обычной работе, но сейчас прям жизненно)
2. Многозадачность
Одновременно заниматься более, чем одним проектом.
3. Аве, Цезарь
Делать три проекта сразу (золотая ачивка "Многозадачность").
4. Обойдусь одной рукой
Вбивать команды, не отпуская мышь (желательно делать это громко).
5. Железный желудок
Вспомнить про обед в половине шестого вечера.
6. Последний герой
Остаться последним сотрудником в офисе вечером, не зная, как закрыть помещение.
7. Я тут живу
Завести на работе зарядные устройства для телефона, часов и наушников.
8. Рука помощи
Забрать альбом в работу у неуспевающего коллеги.
9. Змей-Горыныч
"Работать" на трех мониторах в AutoCAD, WhatsApp и Pikabu
10. Мои вкусы весьма специфичны
Редактировать чертежи в PDF.
11. Клинопись
"Взорвать" штриховку и текст в файле.
12. Археология
Найти первую, оригинальную ревизию альбома.
13. Идеальный порядок
После загрузки на сервер, удалить у себя неактуальные файлы.
14. Герберт Уэст – реаниматор
Успешно восстановить файлы, поврежденные при краше AutoCAD.